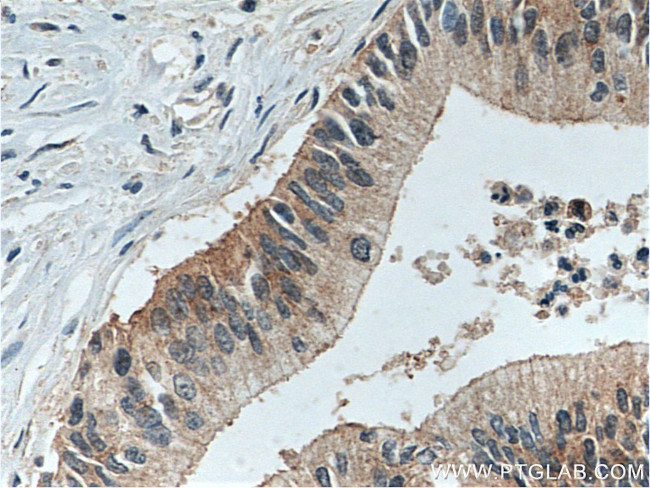
LIV-1/ZIP6 Antibody in Immunohistochemistry (Paraffin) (IHC (P))

Search
Proteintech
LIV-1/ZIP6 Polyclonal Antibody
{{$productOrderCtrl.translations['antibody.pdp.commerceCard.promotion.promotions']}}
{{$productOrderCtrl.translations['antibody.pdp.commerceCard.promotion.viewpromo']}}
{{$productOrderCtrl.translations['antibody.pdp.commerceCard.promotion.promocode']}}: {{promo.promoCode}} {{promo.promoTitle}} {{promo.promoDescription}}. {{$productOrderCtrl.translations['antibody.pdp.commerceCard.promotion.learnmore']}}
产品信息
14236-1-AP
种属反应
已发表种属
宿主/亚型
分类
类型
抗原
偶联物
形式
浓度
规格
纯化类型
保存液
内含物
保存条件
运输条件
产品详细信息
Immunogen sequence: HLLPHSHAS HHHSHSHEEP AMEMKRGPLF SHLSSQNIEE SAYFDSTWKG LTALGGLYFM FLVEHVLTLI KQFKDKKKKN QKKPENDDDV EIKKQLSKYE SQLSTNEEKV DTDDRTEGYL RADSQEPSHF DSQQPAVLEE EEVMIAHAHP QEVYNEYVPR GCKNKCHSHF HDTLGQSDDL IHHH (101-283 aa encoded by B C039498)
靶标信息
This gene encodes a protein which interacts with the carboxy-terminus of transcription initiation factor TFIIF, a transcription factor which regulates elongation as well as initiation by RNA polymerase II. The protein may also represent a component of an RNA polymerase II holoenzyme complex. Alternative splicing of this gene results in two transcript variants encoding 2 different isoforms.
仅用于科研。不用于诊断过程。未经明确授权不得转售。
生物信息学
蛋白别名: endoplasmic reticulum membrane protein; Endoplasmic reticulum membrane-linked protein; Ermelin; Estrogen-regulated protein LIV-1; LIV-1 protein, estrogen regulated; slc39a6 {ECO:0000312|EMBL:AAH97493.1}; solute carrier family 39 (metal ion transporter), member 6; solute carrier family 39 (zinc transporter), member 6; Solute carrier family 39 member 6; unnamed protein product; zinc transporter 6; Zinc transporter ZIP6; ZIP-6; Zrt- and Irt-like protein 6; ZRT/IRT-like protein 6
基因别名: Ermelin; LIV-1; LIV1; SLC39A6; ZIP6
UniProt ID: (Human) Q13433, (Mouse) Q7TQE0, (Rat) Q4V887
Entrez Gene ID: (Human) 25800, (Mouse) 106957, (Rat) 291733